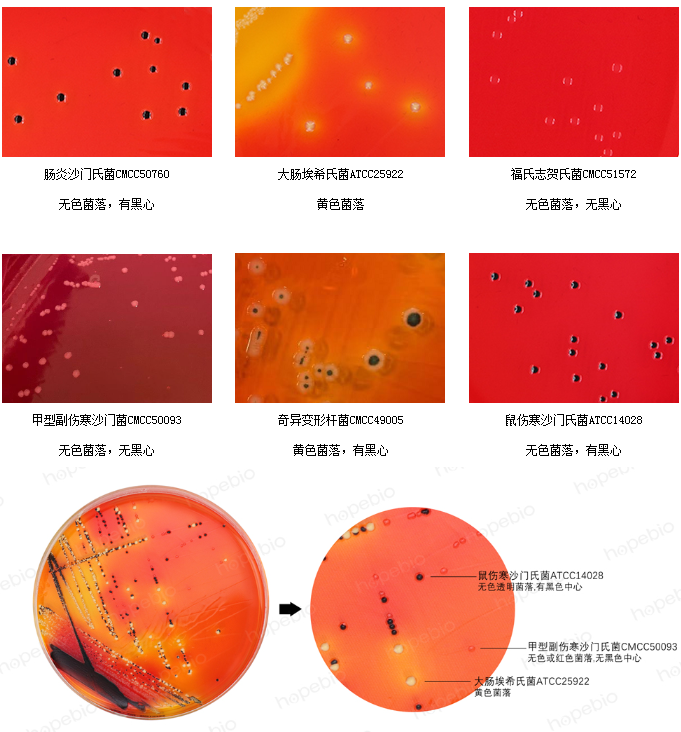
89759614.png

HBPM011 XLD培养基平板
发布时间 :2025-05-22 发布人:yumiaoshengwu 浏览量:递增失败!
基本信息
检验原理:酵母浸粉为细菌生长提供维生素和辅助因子,木糖、乳糖和蔗糖作为可发酵碳源。除志贺氏菌外,其他大多数肠杆菌均发酵木糖,加入赖氨酸是为了鉴别沙门氏菌。沙门氏菌发酵木糖产酸,形成的酸性环境有利于该菌产生脱羧酶,沙门氏菌使赖氨酸脱羧,从而使培养基的pH 升高向碱性转变,但这种转变可因其他菌发酵乳糖和蔗糖产生大量的酸而被阻止。在碱性的条件下,硫代硫酸钠及柠檬酸铁铵与沙门氏菌产生的硫化氢反应,使得菌落的颜色呈黑色;但当酸性条件下时,这种反应被抑制。苯酚红作为酸碱指示剂,氯化钠维持体系渗透压平衡,去氧胆酸盐抑制革兰氏阳性菌的生长。
产品特性
注意事项:本产品仅用于体外诊断,不具有微生物鉴别和药敏鉴别的作用。
XLD培养基平板上细菌的菌落特征:在 XLD 培养基平板上,沙门氏菌通常呈现黑色菌落、黄色菌落且带或不带黑色中心等特征,志贺氏菌一般呈无色至淡红色菌落。